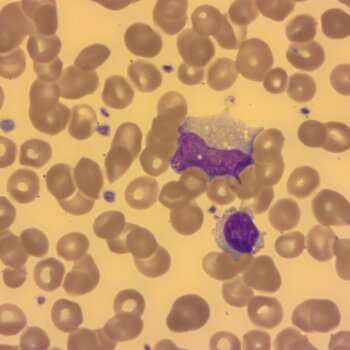
mikroskop_2.jpg

Hematologická laboratoř je od února 2019 nově vybavena automatickým systémem pro barvení krevních nátěrů Hematek a mikroskopem Axio s připojením kamery a možností zálohování nálezů. Tyto přístroje jsou využívány k upřesnění diagnostiky zejména u pacientů po transplantaci solidních orgánů a u pacientů v septickém stavu.